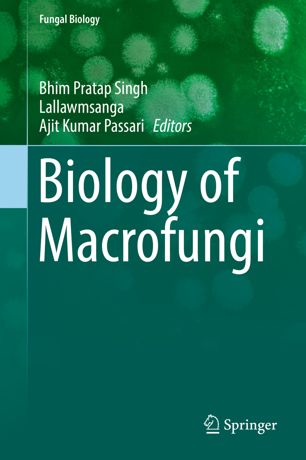

Biology of Macrofungi
BHD 15,00
Order Via Whatsapp
Colour Matt Finished
SKU: 978-3030026219
Category: Biology Books
Tags: Biology Books Available in Abu Dhabi, Biology Books Available in Ajman, Biology Books Available in Al Ain, Biology Books Available in Al Fujayrah, Biology Books Available in Al Hofuf, Biology Books Available in Al Jubail, Biology Books Available in Al Kharj, Biology Books Available in Al Mubarraz, Biology Books Available in Bahrain, Biology Books Available in Buraydah, Biology Books Available in Dammam, Biology Books Available in Doha, Biology Books Available in Dubai, Biology Books Available in Jeddah, Biology Books Available in Jordan, Biology Books Available in Khobar, Biology Books Available in Ksa, Biology Books Available in Kuwait, Biology Books Available in Kuwait City, Biology Books Available in Manama, Biology Books Available in Mecca, Biology Books Available in Medina, Biology Books Available in Muscat, Biology Books Available in Oman, Biology Books Available in Qatar, Biology Books Available in Ras al Khaimah, Biology Books Available in Riyadh, Biology Books Available in Saudi Arabia, Biology Books Available in Sharjah, Biology Books Available in Sultanah, Biology Books Available in Tabuk, Biology Books Available in Taif, Biology Books Available in Uae, Biology Books Available in Umm al Qaywayn, Biology Books Available in United Arab Emirates, Biology Books in Abu Dhabi, Biology Books in Ajman, Biology Books in Al Ain, Biology Books in Al Fujayrah, Biology Books in Al Hofuf, Biology Books in Al Jubail, Biology Books in Al Kharj, Biology Books in Al Mubarraz, Biology Books in Bahrain, Biology Books in Buraydah, Biology Books in Dammam, Biology Books in Doha, Biology Books in Dubai, Biology Books in Jeddah, Biology Books in Jordan, Biology Books in Khobar, Biology Books in Ksa, Biology Books in Kuwait, Biology Books in Kuwait City, Biology Books in Manama, Biology Books in Mecca, Biology Books in Medina, Biology Books in Muscat, Biology Books in Oman, Biology Books in Qatar, Biology Books in Ras al Khaimah, Biology Books in Riyadh, Biology Books in Saudi Arabia, Biology Books in Sharjah, Biology Books in Sultanah, Biology Books in Tabuk, Biology Books in Taif, Biology Books in Uae, Biology Books in Umm al Qaywayn, Biology Books in United Arab Emirates
Description
9783030026219
Only logged in customers who have purchased this product may leave a review.
Related products
-

Neural Progenitor Cells Methods and Protocols 2nd Edition
BHD 12,00 Add to cart Order Via Whatsapp -

The TNF Superfamily Methods and Protocols 2nd Edition
BHD 12,00 Add to cart Order Via Whatsapp -

Wilson and Walkers Principles and Techniques of Biochemistry and Molecular Biology 8th Ed
BHD 36,00 Add to cart Order Via Whatsapp -

The COVID 19 Pandemic Epidemiology Molecular Biology and Therapy
BHD 12,00 Add to cart Order Via Whatsapp
Reviews
There are no reviews yet.